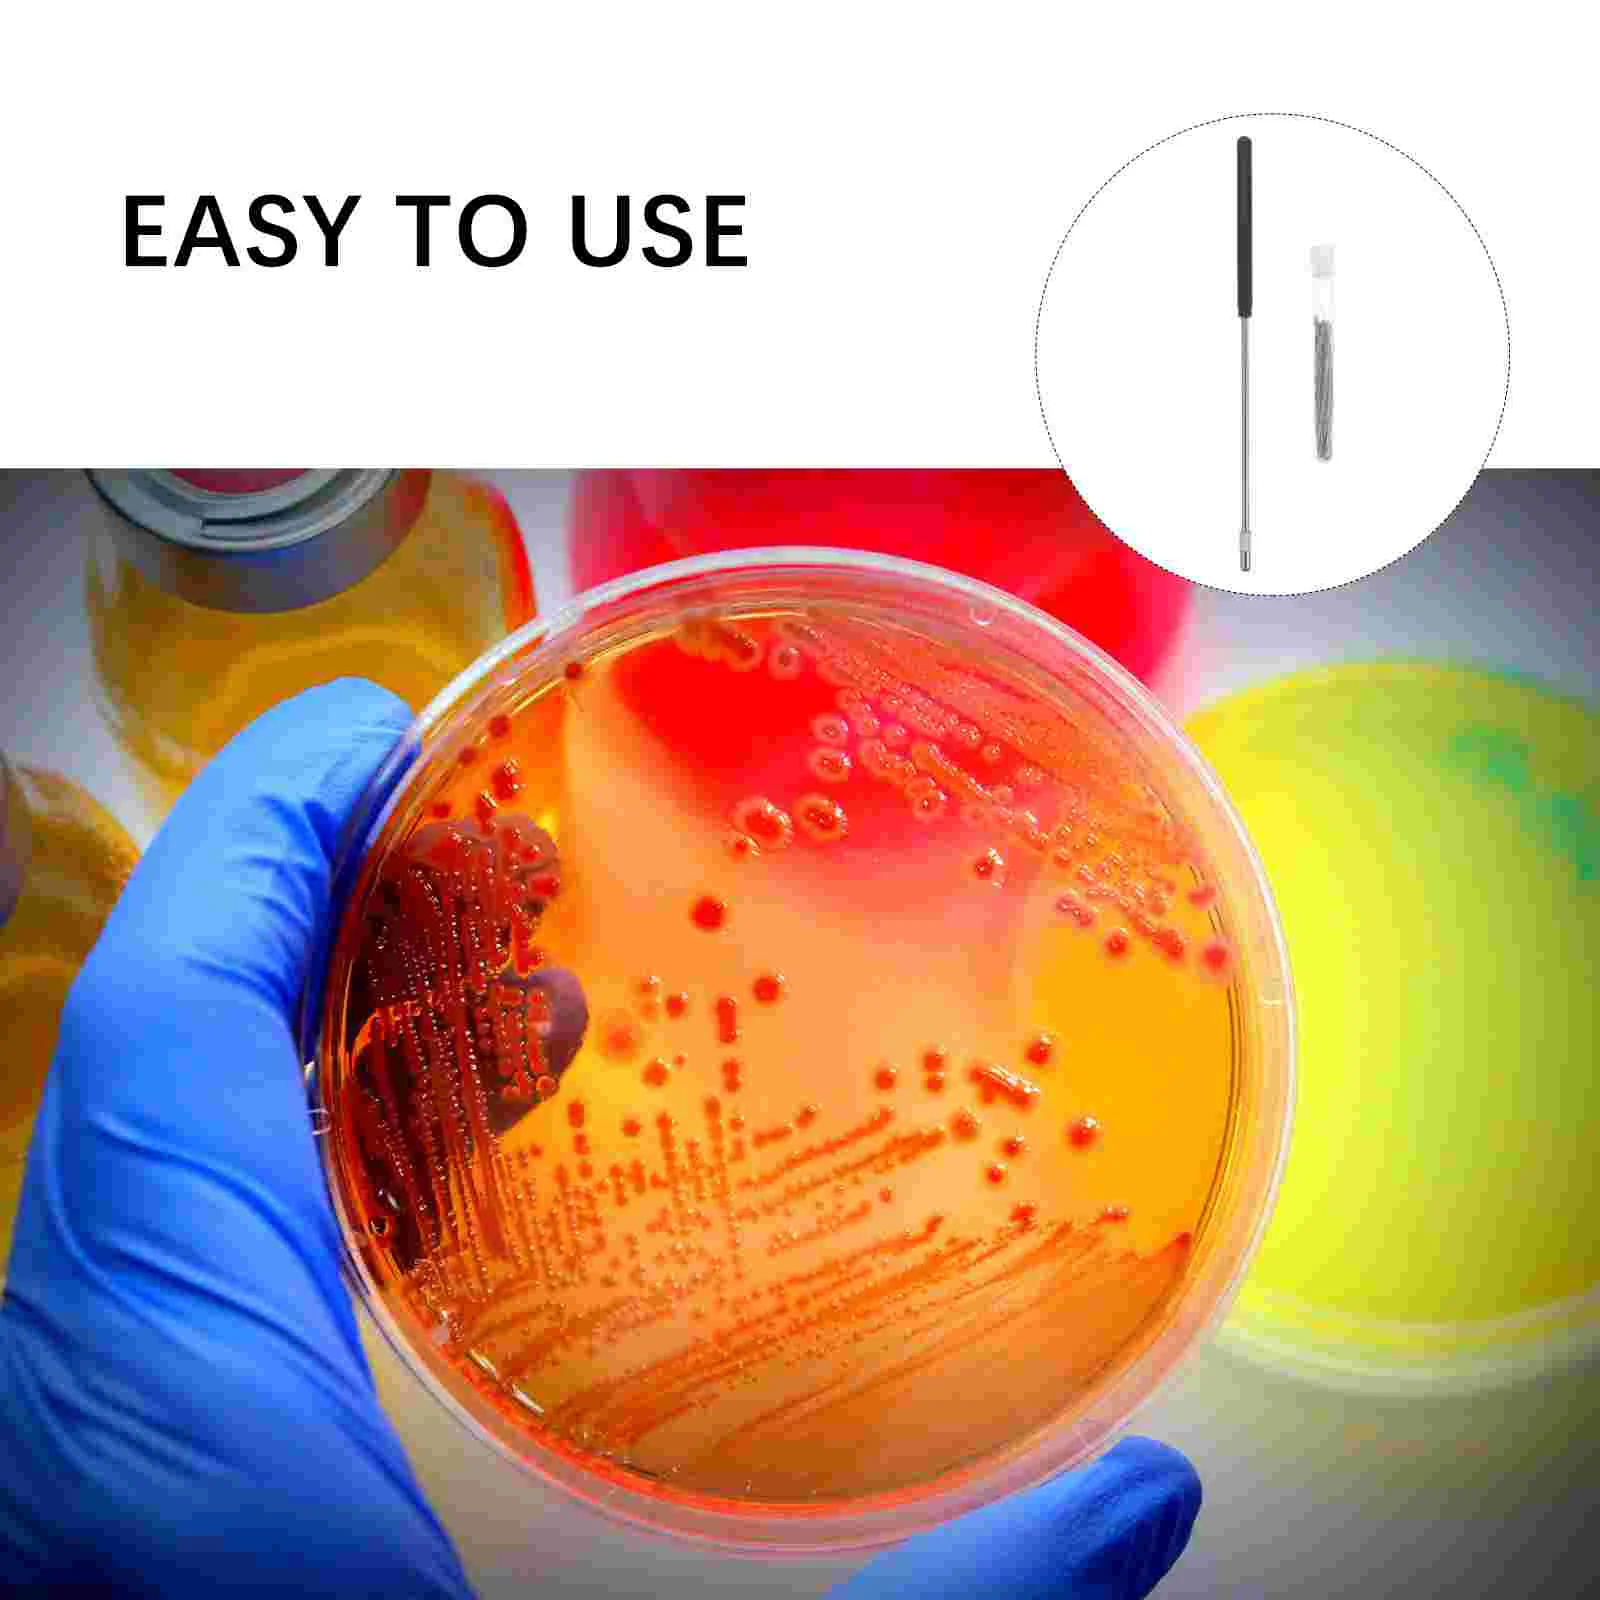
Houder Inenting Staaf Draad Steriele Microbiologie Inenting Loop Laboratorium Tool

- Huis
- Beste verkopers
-
Alle categorieën
- Alle categorieën
- Dameskleding
- Herenkleding
- telefoons en telecommunicatie
- Computer & Office
- consumentenelektronica
- sieraden & Accessoires
- Huis & Tuin
- bagage en tassen
- schoenen
- Sportschoenen, kleding en accessoires
- voedsel
- kleding Accessoires
- home improvement
- hair extensions en pruiken
- Novelty & Speciale gebruik
- Licht & Verlichting
- huishoudelijke apparaten
- Motorfiets apparatuur & onderdelen
- Meubilair
- Accessoires voor telefoons en telecommunicatie
- Ondergoed, Sokken, Sleep & Lounge Wear
- Gereedschap
- Kantoor & School Supplies
- Auto's & Motoren
- Speelgoed & Hobbies
- Boeken en culturele artikelen
- schoonheid en gezondheid
- Test category 06
- moeder en kinderen
- newlv1categorytest
- Bruiloften & Feesten
- Veiligheid & bescherming
- Sports& entertainment
- Industrieel en zakelijk
- Horloges
- Elektronische componenten& benodigdheden
- Alle winkels